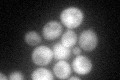
YJR069C
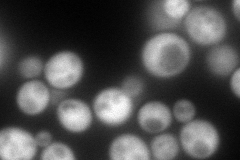
YJR069C
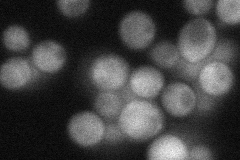
YJR069C
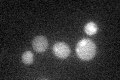
YJR069C

View description
Conserved protein with deoxyribonucleoside triphosphate pyrophosphohydrolase activity, mediates exclusion of noncanonical purines from deoxyribonucleoside triphosphate pools; mutant is sensitive to the base analog 6-N-hydroxylaminopurine
Localization:
Intensity:
Fold change:
Significance:
-
C’ GFP library in SD
cytosol55.91 -
N' NOP1pr-GFP in SD
cytosol224.003 -
N' TEF2pr-mCherry in SD

cytosol281.926 -
N' NATIVEpr-GFP in SD
cytosol51.2769 -
N' TEF2pr-VC and Cyto-VN in SD

#N/A0 -
C’ GFP library in SD+DTT

cytosol54.810.98No -
C’ GFP library in SD+H2O2

cytosol49.970.89No -
C’ GFP library in Starvation Media
cytosol34.950.62No -
C’ GFP library on the background of Pup2-DaMP

cytosol -
C’ GFP library on the background of CCT mutant

cytosol52.67670.942005No
